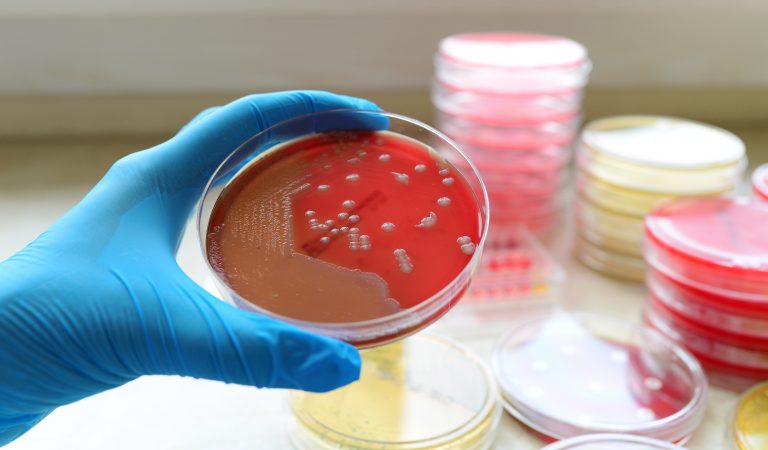
Bacterial ‘striptease’ evades antibiotics

Bacteria | Health | Health news | Healthcare
Bacterial ‘striptease’ evades antibiotics
This article was taken from: https://www.bbc.co.uk/news/health-49826085 By James GallagherHealth and science correspondent, BBC News Bacteria have been caught “stripping off” in order to evade antibiotics and survive, scientists show. Researchers at Newcastle University filmed bacteria “undressing” and taking off their outer layer – or cell wall. Antibiotics can attack cell walls so scientists think this is…